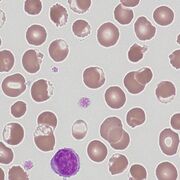
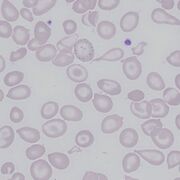
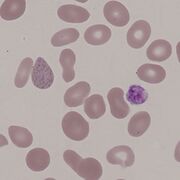
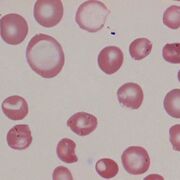
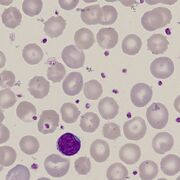
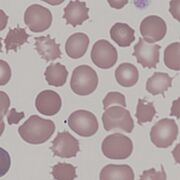
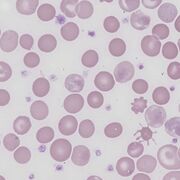
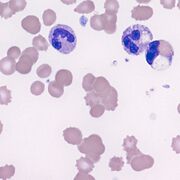
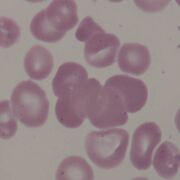

Uploads by John
This special page shows all uploaded files.
| Date | Name | Thumbnail | Size | Description | Versions |
|---|---|---|---|---|---|
| 12:12, 10 March 2023 | TC3.jpg (file) |  |
108 KB | 1 | |
| 12:12, 10 March 2023 | TC2.jpg (file) |  |
54 KB | 1 | |
| 12:11, 10 March 2023 | TC1.png (file) |  |
63 KB | 1 | |
| 12:30, 9 March 2023 | Ec6.jpg (file) |  |
45 KB | 1 | |
| 12:30, 9 March 2023 | Ec5.jpg (file) |  |
49 KB | 1 | |
| 12:29, 9 March 2023 | Ec4.jpg (file) |  |
53 KB | 1 | |
| 12:29, 9 March 2023 | Ec3.jpg (file) |  |
53 KB | 1 | |
| 12:29, 9 March 2023 | Ec2.jpg (file) |  |
32 KB | 1 | |
| 12:29, 9 March 2023 | Ec1.png (file) |  |
106 KB | 1 | |
| 12:22, 9 March 2023 | Boat5.jpg (file) |  |
63 KB | 1 | |
| 12:21, 9 March 2023 | Boat4.jpg (file) |  |
53 KB | 1 | |
| 12:21, 9 March 2023 | Boat3.jpg (file) |  |
46 KB | 1 | |
| 12:03, 9 March 2023 | Boat2.jpg (file) |  |
36 KB | 1 | |
| 12:03, 9 March 2023 | Boat1.png (file) |  |
60 KB | 1 | |
| 11:51, 9 March 2023 | HG5.jpg (file) |  |
111 KB | 1 | |
| 11:50, 9 March 2023 | HG4.jpg (file) | |
115 KB | 1 | |
| 11:50, 9 March 2023 | HG3.jpg (file) |  |
62 KB | 1 | |
| 11:50, 9 March 2023 | HG2.jpg (file) |  |
68 KB | 1 | |
| 11:42, 9 March 2023 | HG1.png (file) |  |
58 KB | 1 | |
| 20:09, 8 March 2023 | Kt5.jpg (file) |  |
55 KB | 1 | |
| 20:08, 8 March 2023 | Kt4.jpg (file) |  |
67 KB | 1 | |
| 20:08, 8 March 2023 | Kt3.jpg (file) |  |
60 KB | 1 | |
| 20:08, 8 March 2023 | Kt2.jpg (file) |  |
43 KB | 1 | |
| 20:07, 8 March 2023 | Kt1.png (file) |  |
76 KB | 1 | |
| 13:25, 8 March 2023 | BS6.jpg (file) | |
42 KB | 1 | |
| 13:25, 8 March 2023 | BS5.jpg (file) |  |
33 KB | 1 | |
| 13:24, 8 March 2023 | BS4.jpg (file) |  |
90 KB | 1 | |
| 13:24, 8 March 2023 | BS3.jpg (file) | |
74 KB | 1 | |
| 13:24, 8 March 2023 | BS2.jpg (file) |  |
27 KB | 1 | |
| 13:16, 8 March 2023 | BS1.png (file) |  |
96 KB | 1 | |
| 17:32, 6 March 2023 | Getting fixed.jpg (file) |  |
94 KB | 1 | |
| 16:13, 6 March 2023 | Anisocytosis 2.jpg (file) |  |
54 KB | 1 | |
| 16:12, 6 March 2023 | Anisocytosis 1.jpg (file) | |
56 KB | 1 | |
| 16:12, 6 March 2023 | RC F anisocytosis G.jpg (file) |  |
27 KB | 1 | |
| 16:12, 6 March 2023 | RC C anisocytosis G.jpg (file) |  |
49 KB | 1 | |
| 13:57, 6 March 2023 | Anisochromia 2.jpg (file) |  |
91 KB | 1 | |
| 13:56, 6 March 2023 | Anisochromia 1.jpg (file) |  |
332 KB | 1 | |
| 13:48, 6 March 2023 | RC C anisochromia G.png (file) |  |
163 KB | 1 | |
| 13:43, 6 March 2023 | RC F anisochromia G.jpg (file) |  |
85 KB | 1 | |
| 16:13, 27 February 2023 | Ac6.jpg (file) | |
56 KB | 1 | |
| 16:13, 27 February 2023 | Ac5.jpg (file) | |
46 KB | 1 | |
| 16:13, 27 February 2023 | Ac4.jpg (file) |  |
63 KB | 1 | |
| 16:12, 27 February 2023 | Ac3.jpg (file) | |
48 KB | 1 | |
| 16:07, 27 February 2023 | AC2.png (file) |  |
184 KB | 1 | |
| 16:07, 27 February 2023 | AC1.png (file) |  |
53 KB | 1 | |
| 23:11, 20 February 2023 | Agglutination3.jpg (file) | |
80 KB | 1 | |
| 23:11, 20 February 2023 | Agglutination2.jpg (file) |  |
53 KB | 1 | |
| 23:11, 20 February 2023 | Agglutination1.jpg (file) |  |
70 KB | 1 | |
| 22:10, 20 February 2023 | RC F Agglutination G.jpg (file) | |
28 KB | 1 | |
| 17:28, 20 February 2023 | RC C agglutination G.png (file) |  |
133 KB | 1 |